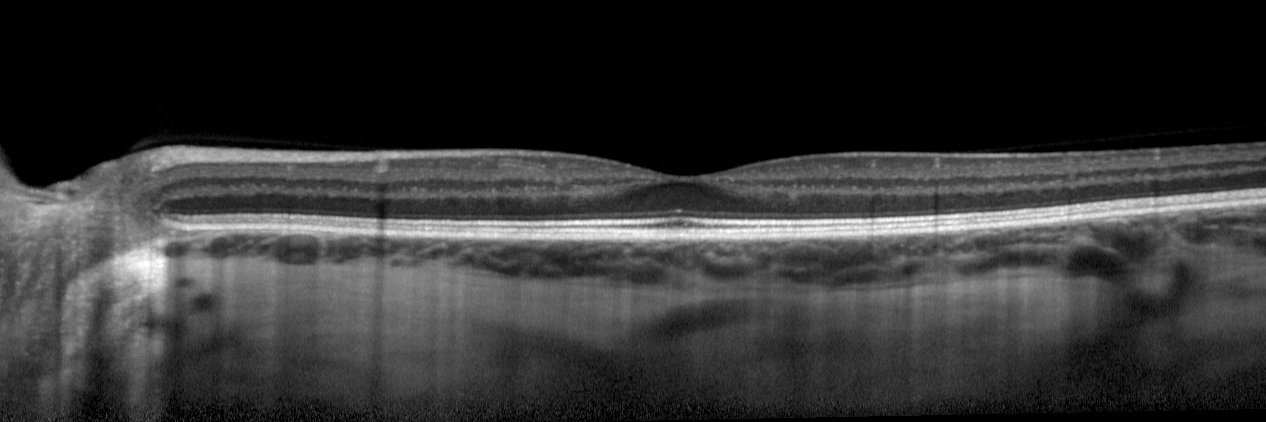
Christine A. Curcio PhD banner

Christine A. Curcio PhD
415 posts

Christine A. Curcio PhD
@AMD_histo_lab
AMD.Lab directed by Christine A. Curcio PhD - focused on clinical imaging validation for age-related macular degeneration. Tweets & opinions = my own.
















Zhihong Jewel Hu et al. @DohenyEye @AMD_histo_lab investigate the relationship between delayed rod-mediated dark adaptation and the status of outer retinal bands on OCT in early and intermediate AMD. doi.org/10.1167/iovs.6…

Uh wait, mechanoreceptors around the eye? Would you elaborate on that? I'd love to learn a lot more.


A big thank you to @dkrizaj from @MoranEyeCenter, for sharing your expertise as an invited speaker at our #RichLectureSeries. Your insights have enlightened and inspired!

Zhihong Jewel Hu et al. @DohenyEye @AMD_histo_lab investigate the relationship between delayed rod-mediated dark adaptation and the status of outer retinal bands on OCT in early and intermediate AMD. doi.org/10.1167/iovs.6…






A heartfelt thank you to Michael Do, PhD, from @harvardmed for sharing his expertise and insights during the #RichLectureSeries. His talk on "Origins of High-Acuity Vision" was illuminating!



I'm deeply saddened to share that we have lost a remarkable friend, a wonderful mentor and esteemed colleague, Judith Campisi. Judith's impact on those around her was profound and lasting. Her legacy will continue to inspire us all. Rest in peace, Judy. You will be greatly missed



